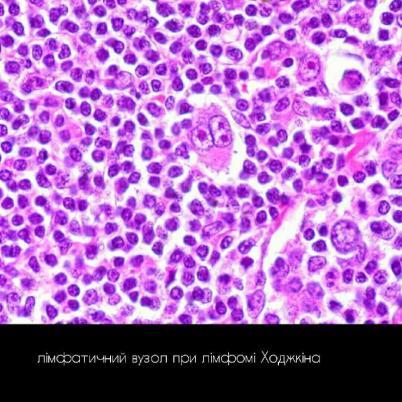

-хвороби, в основі яких лежить лімфоїдна гіперметаплазія кровотворних органів, яка часто супроводжується лімфоїдною інфільтрацією інших органів і тканин; лімфопроліферативні захворювання.
|
Діагноз |
Хронічний лімфолейкоз |
Лімфоматоз шкіри (хв.Сезарі) |
|
Походження пухлинних клітин |
Нативні В-клітини та клітини пам’яті, що не здатні продукувати імуноглобуліни. |
Пухлинні хелперні Т-клітини, клітини Сезарі. |
|
Генотип |
Трисомія по 12-й хромосомі, делеції 11q, 13q і 17p хромосомах. |
Специфічні хромосомні мутації відсутні. |
|
Молекулярний патогенез |
Ріст пухлин обмежений центрами проліферації, в яких стромальні пухлини екскретують фактори, що стимулюють активацію фактора транскрипції NF-kB – активація росту та виживання пухлинних клітин. |
Пухлинні клітини експресують молекули адгезії CLA і рецептори хемокінів CCR4, CCR10 що сприяють міграції Т-лімфоцитів CD4+ до шкіри. |
|
Контингент хворих |
Люди похилого віку з ураженнями КМ, ЛВ, селезінки, печінки. |
Дорослі, що хворіють генералізованими еритемами, мають бляшки та вузли на шкірі. |
|
Морфологія:
|
ЛВ містять малі лімфоцити з неправильної форми ядрами, конденсованими хроматином та бідною цитоплазмою; та пролімфоцити з центрально розміщеним великим ядром, що формують центри проліферації. Кров містить малі лімфоцити, що при виготовленні мазку дегенерують, утворюючи «тіні Гумпрехта»; КМ, селезінка та портальна система печінки інфільтровані малими лімфоцитами.
КМ: червоний, проте в діалізах є осередки жовтого кольору;витіснення лімфоцитарними інфільтратами мієлоїдного ростка. ЛВ: різко збільшені, м’які/щільні, біло-рожеві на розрізі; інфільтрати в капсулі. Селезінка: різко збільшена, червоного кольору, м’ясистої консистенції; інфільтрати розростаються у червоній пульпі, з’єднуючись між собою. Печінка: збільшена, щільна, світло-коричнева з дрібними сіро-білими вузликами на поверхні; лімфоцитарна інфільтрація по ходу портальної системи; білкова і жирова дистрофія. Міокард, брижі, серозні і слизові оболонки – вузли значних розмірів. |
Епідерміс та верхній шар дерми інфільтрований непластичними Т-клітинами, що мають мозговидні ядрами за рахунок складчастої ядерної мембрани.
Шкіра вражається хронічним запальним процесом -генералізованою екзофоліативною еритродермією. На пізніх стадіях пухлина може поширюється до КМ, периферичних ЛВ, селезінки. |
|
Клінічна картина |
Лімфопроліферативний синдром зумовлений лімфаденопатією: симптоми загальної інтоксикації, сплено-/гепатомегалія, лейкемічні інфільтрати, симптоми стиснення. Синдром ускладнень: вторинна інфекція; гемолітична хвороба; синдром Ріхтера – трансформація у агресивну В-крупноклітинну лімфому. |
Проявляється генералізованою екзофоліативною еритродермією. Перебіг не агресивний. |
Хронічні лейкози лімфоцитарного походження – визначення, різновиди, хронічні парапротеїнемічні лейкози: мієломна хвороба клініко-анатомічна та патоморфологічна характеристика, наслідки.
+
Хронічні лейкози лімфоцитарного походження – визначення, різновиди, хронічні парапротеїнімічні лейкози: первинна макроглобулінемія та хвороба тяжких ланцюгів: клініко-анатомічна та патоморфологічна характеристика, наслідки.
|
Парапротеїнемічні лейкози (дискразії)- злоякісні імунопроліферативні захворювання, що мають здатність синтезувати парапротеїни (однорідні імуноглобуліни, або їх фрагменти). |
|||
|
Діагноз |
Мієломна хвороба |
Первинна макроглобулінемія Вальденстрема |
Хвороба тяжких ланцюгів Франкліна |
|
Походження пухлинних клітин |
Плазматичні клітини, що покинули гермінативний центр, і мігрували в кістковий мозок. Розрізняють такі мієломні клітини:
(поліморфноклітинні, дрібноклітинні) |
Плазматичні клітини, що покинули гермінативний центр, і мігрують до екстрамедулярних центрів гемопоезу. |
Плазматичні клітини, що покинули гермінативний центр, і мігрують екстрамедулярних центрів гемопоезу. |
|
Генотип |
Перебудови гену тяжких ланцюгів Ig, делеції і хромосомі 13q. |
Делеція 6q хромосоми. |
Точкові мутації константного домену СН1. |
|
Синтез патологічних імуноглобулінів та їх фрагментів. |
Моноклональні антитіла, обмежені плазмою і позаклітинною рідиною – найбільш часті IgG, але можуть бути і інші форми; вільні легкі ланцюги – білок Бенс-Джонса проникний через нефротичний бар’єр, тому виявляється в сечі. Біохімічні варіанти мієломи: А, Д, Е, Бенс-Джонса. |
Моноклональні антитіла, обмежені плазмою і позаклітинною рідиною – найбільш часті IgМ (білок М). |
Важкі ланцюги α-HCD, γ-HCD, µ-HCD відповідно IgA, IgG, IgM |
|
Контингент хворих |
Люди похилого віку з ліричними ураженнями кісток, гіперкальціємією та нирковою не достатністю |
Люди похилого віку, частіше в поєднанні з лімфоплазмоцитарною лімфомою. |
Рідкісне захворювання, що здебільшого зустрічається у пацієнтів із лімфоплазматичною лімфомою та лімфомою маргінальної зони. |
|
Морфологія |
1.Мікро- В КМ плазматичні клітини інфільтрують інтерстицій пластами, мають перинуклеарне просвітлення (розвинений а.Гольджі) і ексцентричне ядро; плазмобласти з конденсованим хроматином та добре вираженим ядерцем; химерні багатоядерні клітини. Внаслідок порушення синтезу імуноглобулінів з’являються клітини з включеннями інтактних або денатурованих білків: клітини з яскраво-червоною цитоплазмою, кл. Мота з множинними цитоплазматичними вакуолями, клітини з включеннями фібрил, паличкоподібних кристалів, глобул Русселя, тілець Датчера.
КМ: дифузна форма (дифузна мієломна інфільтрація і остеопороз); дифузно-вузлова (дифузний мієломатоз і пухлинні вузли); множинно-вузлова (відсутня мієломна інфільтрація). Кісткова тканина: «пазушне розсмоктування» (розрідження кісткової речовини за рахунок активації остеобластів, відслоювання ендоосту, канали остенів стають широкими); остеолізис, остеопороз – гіперкальціємія – вапняні метастази. Селезінка, печінка, легені, ЛВ –мієломна інфільтрація. Нирки:склероз мозкової і кіркової речовини за рахунок накопичення білку Б-Д, зморщування. |
( пухлинний інфільтрат складається з клітин, схожих як при мієломі).
Збільшені та інфільтровані селезінка, печінка та ЛВ. КМ – рідко.
|
( пухлинний інфільтрат складається з клітин, схожих як при мієломі). 1.Макро Збільшені та інфільтровані селезінка, печінка та ЛВ. КМ – рідко. |
|
Клініка |
Секреція парапротеїнів: амілоїдоз AL, відкладання амілоїду/кристалічних речовин, парапротеїнемічний набряк. Мієломна нефропатія. Синдром підвищеної в’язкості. Парапротеїнемічна кома. Аутоінфекція. |
Геморагічний синдром – геморагії Підвищення в’язкості крові – престази/ стази. Парапротеїнемічна ретинопатія. Амілоїдоз.
|
Гіпогамаальбумінемія – аутоінфекція, сепсис. |
Хронічні лейкози моноцитарного походження – визначення, різновиди, клініко-анатомічна та патоморфологічна характеристика, наслідки.
Моноцитарного походження
І. Пухлини з гістіоцитів (« гістіоцитози»)- походять з тканинних макрофагів:
Реактивний гістіоцитоз синусів лімфатичних вузлів;
Гістіоцитарна саркома .
ІІ. Пухлини із дендритних клітин:
Саркома з клітин Лангерганса;
Саркома інтердигітуючих і фолікулярних дендритних клітин;
Гістіоцитоз із клітин Лангерганса (гістіоцитоз Х)
-мікроморфологія: клонанальна проліферація дендритних антиген-репризентуючих клітин Лангерганса, що експресують антиген CD1; характерними для них є наявність в цитоплазмі НХ- тілець (гранули Бірбека), що нагадують тенісну ракетку; виражена вакуолізація цитоплазми .
-макроморфологія: інфільтрація пухлинними клітинами шкіри, кісткового мозку, гепатоспленомегалія; деструктивні остеолітичні зміни кісткової тканини
Лімфоми. Визначення, класифікація. Лімфома Беркіта –– етіологія, гістологічна характеристика.
Лімфоми-регіональні пухлинні захворювання кровотворної та ліфатичної системи.
До цієї групи захворювань відносять-
1.лімфосаркому
2.грибкоподібний мікоз
3.хворобу Сезарі
4.ретикулосаркому
5.лімфогранелуматоз (хвороба Ходжкіна)
За походженням лімфоми бувають-1.В-клітинні 2.Т-клітинні.
Класифікація Люкез і Колінс:
В-клітинні лімфоми поділяють на-
1.Дрібноклітинні
2.Центроцитарні
3.Імунобластні
4.Плазмоклітинні
Т-клітинні на-
1.Дрібноклітинні
2.З лімфоцитів з перекрученими ядрами
3.Представлені грибковидним мікозом і хворобою Сезарі.
Лімфома Беркіта-ендемічне захворювання ,зустрічається серед населення екваторіальної африки, хворіють частіше діти 4-8 років.
Виникнення лімфоми повязують з герпесоподібним вірусом у лімфатичних вузлах.
Пухлина локалізується у верхній або нижній щелепі, в яєчниках, рідше в нирках, наднирникових залозах, лімфатичних вузлах.
Пухлина складається з дрібних лімфоцитоподібних клітин , серед яких зустрічаються великі із світлою цитоплазмою макрофаги, має вигляд зоряного неба.
Лімфоми – визначення, класифікація, грибоподібний мікоз, хвороба Сезарі та ретикулосаркома клініко-анатомічна та патоморфологічна характеристика, наслідки.
Лімфома - це пухлина, що походить із клітин лімфоїдної тканини.
Класифікація лімфом:
Грибоподібний мікоз – відносно доброякісна Т-клітинна лімфома шкіри.
Морфологія: епідерміс та верхній шар дерми інфільтровані Т-клітинами, плазматичними клітинами, фібробластами, еозинофілами, великими клітинами зі значною кількістю мітозів. Всі це клітини і формують пухлинний інфільтрат.
Пухлинні вузли м*які, виступають над поверхнею шкіри, нагадують форму гриба, легко вкриваються виразками. Можуть бути на шкірі, слизових оболонках, у м*язах, внутр. органах.
Клінічно виділяють 3 стадії:
Запальна премікотична
Стадія бляшок
Пухлинна стадія
Хвороба Сезарі – Т-лімфоцитарна лімфома шкіри з лейкемізацією.
Шкіра, кров та кістковий мозок інфільтровані Т-лімфоцитами, атипічними мононуклеарними клітинами з серповидним ядром – клітини Сезарі.
Пухлинні вузли формуються на обличчі, спині, гомілках. Іноді зустрічається пухлинна інфільтрація селезінки, печінки, нирок.
Клінічна
картина:
Проявляється генералізованою екзофоліативною еритродермією. Перебіг не агресивний.
Прогноз у більшості випадків несприятливий, хоча є випадки виправданого радикального лікування.
Ретикулосаркома – злоякісна пухлина, яка складається з ретикулярних клітин та гістіоцитів, які продукують ретикулярні волокна, обплітаючи ними клітини ретикулосаркоми.
Лімфоми – визначення, класифікація, лімфома Ходжкіна, клініко-анатомічна та патоморфологічна характеристика, наслідки.
Лімфома - це пухлина, що походить із клітин лімфоїдної тканини.
Класифікація лімфом:
Лімфогранулематоз,
або хвороба Ходжкіна
–
хронічне рецидивне, рідше гостро
перебігаюче захворювання, при якому
розростання пухлини відбувається
переважно в лімфатичних вузлах.
З перевагою лімфоїдної тканини (лімфогістіоцитарний):
ранні стадії;
мікроскопічно: зрілі лімфоцити + гістіоцити
Нодулярний (вузловий) склероз: – найбільш поширений варіант;
-первинно розв. в середостінні,
- молодий вік;
-мікроскопічно: кл. Рід-Березовського-Штернберга в центрі та лімфоцити, еозинофіли, макрофаги по периферії
- ЕВV-
Змішано-клітинний варіант:
- 2-3 стадії;
-розповсюдження пат.процесу
-мікроскопічно: кл. Рід-Березовського-Штернберга, гігантські клітини Ходжкіна, лімфоцити, еозинофіли, плазматичні кл., нейтрофіли, осередки некрозу та фіброзу
- молоді дорослі та люди 55> років
-ЕВV+
Варіант з пригніченням (витісненням) лімфоїдної тканини:
-несприятливий перебіг
-генералізація процесу
-мікроскопічно: дифузні розростання сполучної тканини + поодинокі атипові клітини або лімфоїдна тканина, витіснена кл. Ходжкіна, Рід-Березовського-Штернберга
-склероз не розвивається
Патоморфологічно:
збільшені медіастинальні, позачеревні лімфовузли, що зростаються між собою в пакети.
Спочатку м*які та соковиті, сірі або сіро-рожеві. В подальшому стають щільними, сухими, некроз+склероз.
При
генералізації хвороби: збільшується
селезінка, набуває пістрявого вигляду
«порфірова селезінка»
Порфірова селезінка
Найбільш характерна ознака: атипові клітини :
Малі кл. Ходжкіна
Великі кл. Ходжкіна
Багатоядерні кл. Рід-Березовського-Штернберга
Лімфоми-регіональні пухлинні захворювання кровотворної та ліфатичної системи.
До цієї групи захворювань відносять-
1.лімфосаркому
2.грибкоподібний мікоз
3.хворобу Сезарі
4.ретикулосаркому
5.лімфогранелуматоз (хвороба Ходжкіна)
За походженням лімфоми бувають-1.В-клітинні 2.Т-клітинні.
Класифікація Люкез і Колінс:
В-клітинні лімфоми поділяють на-
1.Дрібноклітинні
2.Центроцитарні
3.Імунобластні
4.Плазмоклітинні
Т-клітинні на-
1.Дрібноклітинні
2.З лімфоцитів з перекрученими ядрами
3.Представлені грибковидним мікозом і хворобою Сезарі.
Лімфогранулематоз(хвороба Ходжкіна)-хронічне рецидивне , рідше гостре захворювання при якому розростання пухлини відбувається переважно в лімфатичних вузлах.
За морфологічними ознаками виділяють- 1.ізольований 2.розповсюджений гранулематоз.
При ізольованому- зміни в одній групі лімфатичних вузлів: 1.шийні 2.медіастинальні 3.позаочеревинні. 4.рідше пахвові, пахвинні.
Спочатку вузли: 1.мякі 2.соковиті 3.сірі або сіро-рожеві , потім стають 1.щільні 2.сухі 3.з осередками некрозу і склерозу.
Розповсюджений гранулематоз може локалізуватися в : 1.селезінці 2.печінці 3.шлунку 4.легенях 5. шкірі.
В першу чергу збільшується селезінка, на розрізі- 1.пульпа червона з множинними з множинними блідо-жовтими осередками некрозу і склерозу 2. пістрявий «порфировий »вигляд. Притаманні метастази.
Мікроскопічно знаходять 1.проліферацію лімфоцитів 2.гістіоцитів 3.ретикулярник клітин серед яких еозинофіли, плазматичні клітини, нейтрофільні лейкоцити. Утворюються вузлики що підлягають казеозному некрозу і склерозу.